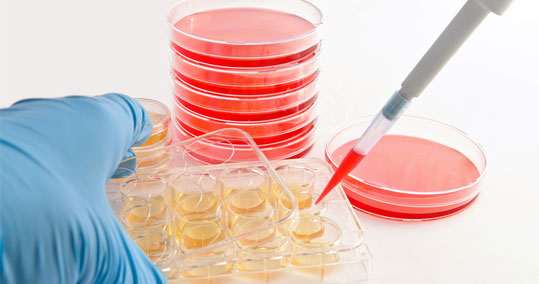

| Η θεραπεία με βλαστοκύτταρα, κατά της σκλήρυνσης κατά πλάκας, έχει εκπληκτικά αποτελέσματα |
Βρετανοί γιατροί ανακοίνωσαν ότι μικρός αριθμός πασχόντων από σκλήρυνση κατά πλάκας παρουσιάζουν «εκπληκτική» βελτίωση έπειτα από τη λήψη θεραπείας με βλαστοκύτταρα.
Περίπου 20 ασθενείς από το Σέφιλντ έχουν υποβληθεί την τελευταία τριετία σε μεταμόσχευση αυτόλογων αιμοποιητικών κυττάρων (HCT) που έχει ως στόχο να αφαιρεθούν τα ανοσοποιητικά κύτταρα που ευθύνονται για την σκλήρυνση και να ξαναρυθμιστεί το ανοσοποιητικό σύστημα.
 Μερικοί από αυτούς, οι οποίοι ήταν παράλυτοι, μπόρεσαν να ξαναπερπατήσουν, δήλωσαν οι βρετανοί επιστήμονες στο πρόγραμμα Panorama του BBC.
«Το να έχουμε μία θεραπεία που είναι πιθανό να αντιστρέφει την αναπηρία αποτελεί ένα πραγματικά σημαντικό επίτευγμα», δήλωσε ο δρ Μπάζιλ Σάρακ, καθηγητής Κλινικής Νευρολογίας στο Ακαδημαϊκό Τμήμα Νευροεπιστήμης του Βασιλικού Νοσοκομείου του Hallamshire, στο Σέφιλντ.
Η σκλήρυνση κατά πλάκας είναι μία εκφυλιστική, αυτοάνοση ασθένεια, που προκαλείται από υπερλειτουργία του ανοσοποιητικού συστήματος, ορισμένα κύτταρα του οποίου επιτίθενται και καταστρέφουν το προστατευτικό «περίβλημα» των νευρικών ινών: την μυελίνη ουσία.
Αυτό έχει ως συνέπεια να πλήττονται τα νεύρα στον εγκέφαλο και το νωτιαίο μυελό, και να εκδηλώνει ο πάσχων διάφορα νευρολογικά συμπτώματα.
Η νόσος, η σύγχρονη ονομασία της οποίας είναι πολλαπλή σκλήρυνση, υπολογίζεται ότι προσβάλλει ένα στα 1.000 άτομα στη χώρα μας, τα οποία συνήθως είναι 20-40 ετών όταν παρουσιάζουν τις πρώτες ύποπτες εκδηλώσεις.
Πέραν του Νοσοκομείου του Hallamshire, στο ερευνητικό πρόγραμμα για τις μεταμοσχεύσεις αυτόλογων αιμοποιητικών κυττάρων συμμετέχουν νοσοκομεία στις ΗΠΑ, τη Σουηδία και τη Βραζιλία, στο πλαίσιο της επονομαζόμενης μελέτης MIST στην οποία αξιολογούνται τα μακροπρόθεσμα οφέλη της μεθόδου.
Οι ασθενείς που συμμετέχουν στην MIST πάσχουν από την υποτροπιάζουσα μορφή της νόσου, η οποία χαρακτηρίζεται από εξάρσεις και υφέσεις.
Η θεραπεία συμπεριλαμβάνει εντατική χημειοθεραπεία και οι ασθενείς προειδοποιούνται ότι μπορεί να εκδηλώσουν ανεπιθύμητες ενέργειες, όπως ναυτία και τριχόπτωση.
Η μελέτη MIST άρχισε το 2006 και επικεφαλής της είναι ο δρ Ρίτσαρντ Μπερτ, καθηγητής και επικεφαλής του Τμήματος Ανοσοθεραπείας & Αυτοάνοσων Νοσημάτων (DIAD) στο Πανεπιστήμιο Northwestern του Σικάγου.
Ο δρ Μπερτ και οι συνεργάτες του είχαν δημοσιεύσει πέρυσι στην «Επιθεώρηση της Αμερικανικής Ιατρικής Εταιρείας» (JAMA) τα προκαταρκτικά ευρήματα από την δοκιμή της μεθόδου σε 145 αμερικανούς ασθενείς, μέσης ηλικίας 36 ετών (το ηλικιακό εύρος ήταν από 18 έως 60 ετών).
Όπως είχαν τότε γράψει, η μεταμόσχευση των αιμοποιητικών βλαστοκυττάρων «συσχετίσθηκε με βελτιώσεις στη νευρολογική αναπηρία των ασθενών και με άλλες (θετικές) κλινικές εκβάσεις» και επομένως «απαιτείται τώρα επιβεβαίωση» αυτών των ευρημάτων.
Τα τελικά αποτελέσματα της μελέτης MIST, που αναμένονται σε περίπου δύο χρόνια, μπορεί να καθορίσουν αν θα αρχίσει η ευρεία χρήση της μεθόδου, σύμφωνα με τους ειδικούς.
|


























